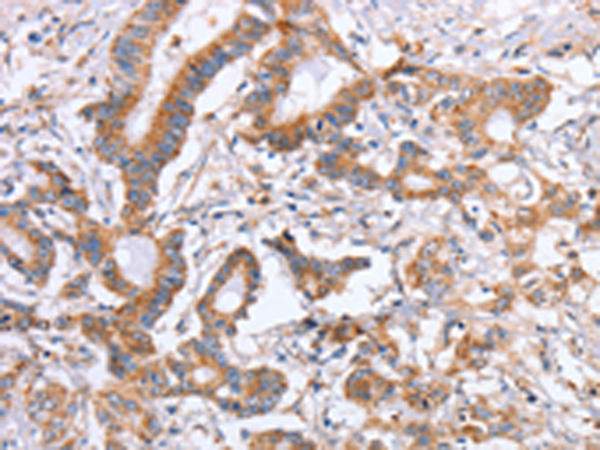
一抗

英文名稱: Anti-ITGB5 rabbit polyclonal antibody
技術規格
|
Background: |
Integrins are heterodimers composed of noncovalently associated transmembrane a and b subunits. The 16 a and 8 b subunits heterodimerize to produce more than 20 different receptors. Most integrin receptors bind ligands that are components of the extracellular matrix, including Fibronectin, Collagen and Vitronectin. Certain integrins can also bind to soluble ligands such as Fibrinogen, or to counterreceptors on adjacent cells such as the intracellular adhesion molecules (ICAMs), leading to aggregation of cells. Ligands serve to cross-link or cluster integrins by binding to adjacent integrin receptors; both receptor clustering and ligand occupancy are necessary for the activation of integrin-mediated responses. In addition to mediating cell adhesion and cytoskeletal organization, integrins function as signaling receptors. |
|
Applications: |
ELISA, IHC |
|
Name of antibody: |
ITGB5 |
|
Immunogen: |
Fusion protein of human ITGB5 |
|
Full name: |
integrin, beta 5 |
|
SwissProt: |
P18084 |
|
ELISA Recommended dilution: |
1000-5000 |
|
IHC positive control: |
Human colon cancer and human thyroid cancer |
|
IHC Recommend dilution: |
25-100 |

 購物車
購物車 幫助
幫助
 021-54845833/15800441009
021-54845833/15800441009